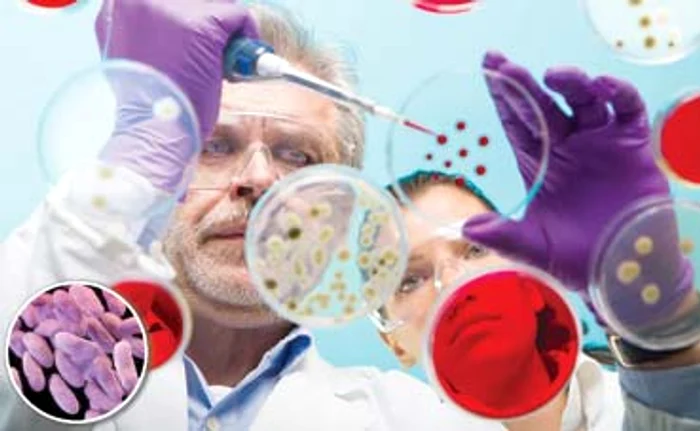
Sindromul Respirator Acut Sever (SARS) a izbucnit în 2003 în sudul Chinei

Superbacteria mutant a învins toate medicamentele

O infecţie pe care o consideram banală în urmă cu câţiva ani ar putea ”decima” omenirea în următorii zeci de ani. Şi asta pentru că cele mai puternice antibiotice folosite în tratament au devenit complet ineficiente. Cele mai sumbre previziuni ale specialiştilor, care avertizează de ani buni că abuzul de antibiotic va duce la un dezastru, s-au adeverit. Este alertă maximă după ce în SUA a fost descoperită o superbacterie rezistentă la orice medicament!
O femeie de 49 de ani, din Pennsylvania a pus pe jar lumea medicală. Americanca a venit la o clinică prezentând simptome de infecţie urinară. Medicii i-au făcut testul de urină şi au constatat că pacienta are bacteria E. coli, tulpina mcr-1. Antibiograma (cea care stabileşte ce antibiotic trebuie folosit) a fost cea care i-a uluit pe toţi: superbacteria s-a dovedit rezistentă la toate antibioticele. Chiar şi la cele mai puternice, cum este, de pildă, Colistinul, pe care medicii îl folosesc în cele mai dificile cazuri, de bacterii multirezistente, potrivit publicaţiei „Huffington Post”.
Directorul Centrului pentru Controlul Bolilor şi Prevenţiei (CDC) din SUA, Tom Frieden, a demarat o amplă anchetă epidemiologică. Este vital de ştiut dacă bacteria s-a răspândit la persoanele cu care pacienta, aflată acum în afara pericolului, a intrat în contact. Specialiştii sunt cu atât mai îngrijoraţi, cu cât un raport arată că acest tip de infecţie poate duce la moartea a jumătate din pacienţii ce o prezintă.
Frieden a avertizat că, deşi este primul caz din SUA, trebuie să ne aşteptăm la alte asemenea superbacterii, în viitorul apropiat. El a făcut apel la cercetători să dezvolte noi medicamente repede. „Dulapul cu medicamente este gol pentru unii pacienţi. Suntem la capătul drumului pentru antibiotice dacă nu acţionăm urgent”, a avertizat el.
La rândul său, premierul britanic David Cameron a făcut apel vineri la liderii ţărilor din G7 pentru ca aceştia să facă mai mult pentru reducerea folosirii antibioticelor, informează Reuters
. „În prea multe cazuri antibioticele nu mai au efect, ceea ce înseamnă că oamenii mor din simple infecţii sau boli precum TBC, tetanos, septicemie, infecţii care nu ar trebui să fie o condamnare la moarte”, a spus Cameron, la o conferinţă de presă din cadrul summitului din Japonia.
„Dacă nu facem nimic, economia lumii va încasa o lovitură totală de 100.000 de miliarde de dolari şi este, probabil, sfârşitul medicinii moderne aşa cum o cunoaştem”, a avertizat premierul britanic.
Bacteriile multirezistente nu sunt o noutate, sunt peste tot în lume, în special în agricultură. Această tulpină de E.coli rezistentă inclusiv la Colistin a fost descoperită pentru prima oară la om în China, în noiembrie 2015. În ceea ce priveşte răspândirea, marea îngrijorare este legată de animalele a căror carne o consumăm (a fost depistat un caz de bacteria, de exemplu, în intestinele unui porc). De aici, şi o avertizare privind folosirea antiobioticelor. Pentru care, aşa cum spun specialiştii, ar putea fi „capătul drumului”.
Cum se transmite şi cum ne ferim de E.coli

Escherichia coli (E. coli) se găseşte în mod obişnuit în tubul digestiv al oamenilor şi animalelor şi se transmite prin contactul direct cu persoane bolnave sau prin consumarea de alimente contaminate. E-coli se găseşte nu doar în intestinul oamenilor, ci şi în apă, carne, fructele şi legumele crude, precum şi în laptele nefiert. Se poate transmite interuman şi prin atingerea mâinilor murdare. Dincolo de regulile generale de igienă cum ar fi spălarea pe mâini cu apă şi săpun după folosirea toaletei, înainte şi după schimbarea scutecelor sau după contactul cu animalele, medicii mai recomandă depozitarea separată a cărnii de alte alimente şi fierberea laptelui înainte de consum. De asemenea, este indicată fierberea pentru două minute, la o temperatură de cel puţin 70 de grade Celsius, a cărnii tocate.
Folosim prea des şi prea multe antibiotice

Considerate unele dintre cele mai importante descoperiri din industria farmaceutică, antibioticele ne arată acum şi „reversul medaliei”. Specialiştii Organizaţiei Mondiale a Sănătăţii (OMS) atrag atenţia de ani de zile asupra faptului că medicii prescriu mult prea uşor şi prea des antibiotice (tratament simplu, de durată scurtă şi foarte eficient), chiar şi atunci când boala ar putea fi combătută cu alte tratamente. În plus, în zootehnie sunt folosite pe scară largă pentru a preveni sau trata infecţiile la păsările şi animalele destinate consumului uman. Consecinţa? Bacteriile s-au „obişnuit” cu aceste tratamente, au devenit rezistente (adică substanţele respective nu le mai ucid). Bolnavul nu mai poate fi tratat şi moare. Statisticile arată că, numai în SUA, în fiecare an, peste 2 milioane de persoane sunt infectate cu bacterii rezistente la antibiotic şi cel puţin 23.000 mor!
Prin ce a trecut omenirea
Până acum, virusurile au fost cele mai grave ameninţări la adresa sănătăţii oamenilor. Iată câte ravagii au făcut şi care au fost cele mai de temut.
- Gripa spaniolă. S-a declanşat în 1918 şi a fost cea mai devastatoare epidemie cunoscută. Se estimează că a ucis între 2 şi 5 la sută din populaţia Terrei şi că 20 la sută din totalul populaţiei a făcut boala. Specialiştii spun că soldaţii care se întorceau de pe front au dus în toate ţările virusul pe care azi îl cunoaştem drept virusul gripei aviare.
- SARS. În anul 2003, omenirea a cunoscut isteria şi ameninţarea Sindromului Respirator Acut Sever (SARS). Izbucnit în provincia Guangdong din sudul Chinei, a fost iniţial ţinut secret de autorităţile chineze, însă turiştii veniţi aici în vacanţe au dus rapid boala în nu mai puţin de 37 de ţări. Bilanţ: peste 750 de morţi (printre care şi un român) şi circa 8.500 de îmbolnăviri.
- Gripa porcină. Extrem de contagioasă, boala declanşată de virusul H1N1 a afectat, conform datelor oficiale, circa 20 la sută din populaţia planetei. Declanşată în 2009, pandemia s-a întins pe durata a 16 luni, iar bilanţul e cutremurător: cel puţin un milion de persoane infectate, dintre care peste 18.500 au murit. În România, au fost confirmate peste 6.200 de cazuri şi au murit 92 de pacienţi.































